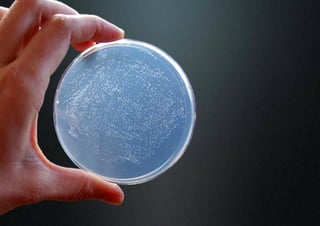

This document describes the creation of antibacterial fibres through the deposition of polyelectrolyte multilayers. The multilayers are formed via a simple water-based process using polyvinylamine (PVAm) and a modified hydrophobic PVAm. Testing showed the multilayers reduced bacterial growth by 50% with just 3 layers. When applied to fibres, the multilayers reduced bacterial removal by over 99.9% and inhibited growth. Oxidizing the fibres further increased these antibacterial effects. Electron microscopy images revealed bacteria attached to untreated fibres were over 1.5 μm long while those on oxidized fibres were under 1 μm, showing contact-active antibacterial properties. The multilayers have potential applications